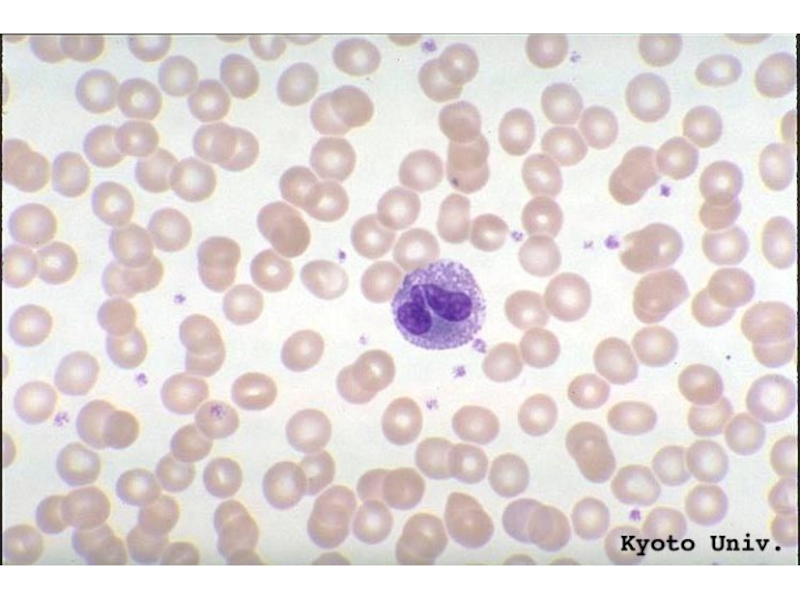

- Главная
- Разное
- Дизайн
- Бизнес и предпринимательство
- Аналитика
- Образование
- Развлечения
- Красота и здоровье
- Финансы
- Государство
- Путешествия
- Спорт
- Недвижимость
- Армия
- Графика
- Культурология
- Еда и кулинария
- Лингвистика
- Английский язык
- Астрономия
- Алгебра
- Биология
- География
- Детские презентации
- Информатика
- История
- Литература
- Маркетинг
- Математика
- Медицина
- Менеджмент
- Музыка
- МХК
- Немецкий язык
- ОБЖ
- Обществознание
- Окружающий мир
- Педагогика
- Русский язык
- Технология
- Физика
- Философия
- Химия
- Шаблоны, картинки для презентаций
- Экология
- Экономика
- Юриспруденция
Лейкоциты. Функции моноцитов. Лимфоциты. Иммунитет презентация
Содержание
- 2. Лейкоциты – белые кровяные клетки, шаровидной формы.
- 4. Увеличение их количества называется лейкоцитозом. Наблюдаются при
- 6. 1. Базофил - от 0 до 1%.
- 7. Базофил
- 8. Функции базофилов Поддержание кровотока в мелких
- 9. 2. Эозинофил - 2-5% от всех лейкоцитов.
- 10. Эозинофилы - клетки аллергии
- 11. Эозинофил
- 14. 3. Нейтрофилы В N – 53-56%
- 16. Нейтрофил
- 17. Нейтрофил поглощает бактерии сибирской язвы
- 18. Эозинофилы – аллергия, нейтрофилы –
- 20. Незернистые формы. Агранулоциты. Моноциты – зернистости в
- 24. Функции моноцитов Участие в иммунном ответе и
- 25. Лимфоциты 24-30% (от лейкоцитов) – мелкие
- 26. Лимфоциты
- 27. «Т» - тимус зависимые дифференцируются и созревают
- 28. Лимфоциты «Т» - клеточный иммунитет «Тh» -
- 29. 5 классов иммуноглобулинов. Иммуноглобулины – это
- 30. Субпопуляции лимфоциов. МН-лимфоциты или естественные киллеры борьба
- 32. Увеличение количества лейкоцитов – лейкоцитоз 1 физиологический
- 33. Лейкопения – уменьшение количества лейкоцитов. Часто
- 34. Лейкоцитарная формула – % соотношение различных видов лейкоцитов.
- 39. Своеобразие нашей иммунной системы: 1) Разбросана
- 41. Иммунитет Естественный (природный) Искусственный (приобретенный)
- 42. Иммунодефицит. 1) физиологический – у новорожденных до 3-6
- 43. Тимус (glandula thymus; син. вилочковая железа) –
- 44. Вилочковая железа (тимус). Играет важнейшую роль
- 45. Регуляция лейкопоэза
- 46. Иммуномодуляторы препараты животного, микробного, дрожжевого и синтетического
- 47. Усиление общей сопротивляемости организма может в той
- 48. иммунологические свойства эндогенных соединений — лимфокинов, интерферонов (терапевтическую
- 49. ИНТЕРФЕРОНЫ - группа низкомолекулярных гликопротеидов, вырабатываемых клетками
- 50. Амиксин — первый таблетированный пероральный низкомолекулярный
Слайд 2Лейкоциты – белые кровяные клетки, шаровидной формы.
Все лейкоциты имеют ядро.
Всего лейкоцитов в периферической крови от
4 до 9*109/л
Слайд 4Увеличение их количества называется лейкоцитозом. Наблюдаются при воспалительных процессах, при пищеварении,
Уменьшение – лейкопенией - возможно при некоторых болезнях.
Слайд 61. Базофил - от 0 до 1%.
крупная фиолетовая зернистость
Продолжительность жизни базофилов 8-12 суток, время циркуляции в периферической крови (как и у всех гранулоцитов) – несколько часов.
Слайд 8Функции базофилов
Поддержание кровотока в мелких сосудах и питания тканей
Поддержание роста
Обеспечение миграции других лейкоцитов
Фагоцитоз и защита от инфекции
Участие в аллергических реакциях
Активация агрегации тромбоцитов
Повышение базофилов — базофилия:
болезни крови (острый лейкоз…)
хронические воспалительные состояния желудочно-кишечного тракта, язвенный колит
аллергические реакции (на введение чужеродного белка, гипер-чувствительность на пищу)
Понижение базофилов — базопения:
острые инфекции
гипертиреоз
овуляция, беременность
стресс
результат действия кортикостероидов, синдром Кушинга
Слайд 92. Эозинофил - 2-5% от всех лейкоцитов.
Эозинофил – имеет ядро
Обладает свойством фагоцитоза. Поглощает токсические вещества и гистамин, поэтому их количество возрастает при аллергиях, глистных инвазиях, различных отравлениях. Снижается их количество при тяжело протекающих инфекциях.
Слайд 143. Нейтрофилы В N – 53-56%
– самая распространенная популяция имеют
- выполняют функцию фагоцитоза чужеродных клеток, микробов, бактерий, вирусов, химических веществ, разных частиц (типа занозы). Нейтрофилы увеличиваются в начале заболевания (напр. при острых бактериальных инфекциях), а затем их количество может резко снижаться за счет их резкой гибели. При этом в костном мозге образуются молодые новые нейтрофилы и в кровь поступают палочкоядерные и юные формы нейтрофилов. Особенно много юных, когда возрастает количество микробов. Их количество повышается при ангинах, пневмониях, при пересадке органов.
Слайд 18
Эозинофилы – аллергия,
нейтрофилы – воспаление. – их увеличение свидетельствует об
Слайд 20Незернистые формы. Агранулоциты.
Моноциты – зернистости в цитоплазме нет. Самые крупные крови
При хронических инфекционных заболеваниях. Участвуют тоже в иммунитете, запоминая часть информации о чужеродных клетках.
Слайд 24Функции моноцитов
Участие в иммунном ответе и воспалении. Обеспечение клеточного и гуморального
Активация регенерации тканей
Участие в противоопухолевой защите
Регуляция гемопоэза
Фагоцитоз микроорганизмов и старых клеток, противопаразитарная защита
Стимуляция центра терморегуляции
Слайд 25Лимфоциты 24-30% (от лейкоцитов)
– мелкие лейкоциты с округлым ядром почти
Цитоплазма остается тонким слоем.
Увеличиваются при вирусных и хронических инфекциях – несут ответственность за специфический иммунный ответ.
Слайд 27«Т» - тимус зависимые дифференцируются и созревают в тимусе.
«В» -
- обеспечивают гуморальный иммунитет
– обеспечивают клеточный иммунитет
Слайд 28Лимфоциты
«Т» - клеточный иммунитет
«Тh» - хелперы (помощники) –
распознают чужеродную
информацию
Т-супрессорам и Т-киллерам.
«Тs» - супрессоры (угнетатели)
– запоминают информацию о
чужеродной клетке и передают
«Тk»-киллер – (убийцы)
поглощают (фагоцитоз),
уничтожают чужеродные
трансплантанты,
клетки-мутанты, что сохраняет
генетический гомеостаз.
«В» - гуморальный иммунитет
реализуется путем выработки
антител (иммуноглобулинов),
которые разрушают и/или
выводят антиген из организма
Конечная цель гуморального
иммунитета — выработка
антител на какой-либо антиген.
Антитела вырабатываются
плазматическими клетками,
которые образуются из
В-лимфоцитов, поэтому
гуморальный иммунитет
иногда называют
В-иммунитетом.
Слайд 295 классов иммуноглобулинов.
Иммуноглобулины – это антитела, которые уничтожают взаимодействуя в процессе
JgA - (a) иммуноглобулин.
Jgg - (джи) иммуноглобулины
Jgm - (м)
JgD
JgE
Слайд 30Субпопуляции лимфоциов.
МН-лимфоциты или естественные киллеры борьба с опухолями;
ТА – к-ки
ТД – к-ки или ТД-лимфоциты следят чтобы дифференцировка шла в нужном направлении;
BS – проводят иммунологический надзор;
О (нулевые) лимфоциты – проводят лизис без комплиментов.
Слайд 32Увеличение количества лейкоцитов – лейкоцитоз
1 физиологический (в основе перераспределение крови) По
Пищевой лейкоцитоз, миогенный – физические нагрузки, лейкоцитоз беременных, новорожденных, при эмоциональных напряжениях, во время наркоза. В основе лежит перераспределение клеток белой крови:
в нем участвуют костный мозг, селезенка, легкие.
2 патологический (реактивный).
Реактивный лейкоцитоз характерен для воспалительных процессов и инфекционных заболеваний. Связан с повышением выброса клеток из органов кроветворения с преобладанием молодых форм.
Слайд 33Лейкопения – уменьшение количества лейкоцитов.
Часто сопровождает длительную лекарственную терапию, поражение
Слайд 39
Своеобразие нашей иммунной системы:
1) Разбросана по всему организму.
2) Клетки находятся в постоянном движении
3) Клетки иммунной системы способны вырабатывать антитела строго специфические.
Слайд 41
Иммунитет
Естественный (природный)
Искусственный (приобретенный)
ВИДОВОЙ
НАСЛЕДСТВННЫЙ
ПРИОБРЕТЕННЫЙ
Пассивный
(с молоком
матери)
Активный
(после
болезни)
Активный
(после
вакцинации
ослабленных или
убитых
возбудителей
заболеваний)
Пассивный
(после введения
Лечебной
Кратковременный
но сразу.
Слайд 42Иммунодефицит.
1) физиологический – у новорожденных до 3-6 месяцев – когда организм ребенка
2) Врожденная форма иммунодифицита – при нарушении функции вилочковой железы, когда нарушается дифференцировка и обучение Т-лимфоцитов выполнять свои функции (уничтожает и сохраняет все в вилочковой железе получают специализацию). Врожденный иммунодифицит – порожает Th – и лимфоциты не способны распознать свой-чужой.
3) Приобретенный иммунодефицит – при нарушении и клеточного и гуморального иммунитета при недостаточном питании и после длительных тяжелых заболеваний, после стрессов, т.к. адреналин угнетает иммунную систему.
Слайд 43Тимус (glandula thymus; син. вилочковая железа) – это парная железа, расположенная
Тимус (вилочковая железа) является центральным органом иммунитета, обеспечивающим продукцию специфических Т-лимфоцитов. Тимоциты секретируют в кровь гормональные факторы(тимозин, тимопоэтин, тимулин), оказывающие не только влияние на дифференцировку Т-клеток. Последние осуществляют главные ф-ции иммунной системы по противовирусной и противораковой защите организма, а также участвуют в отторжении чужеродных тканей при пересадке органов, но и вызывающие ряд общих регуляторных эффектов в организме. Гормоны тимуса регулируют состояние углеводного и белкового обмена, а также обмена кальция, функции щитовидной и половых желез, модулируют эффекты глюкокортикоидов, тироксина (антагонизм) и соматотропина (синергизм).
Слайд 44Вилочковая железа (тимус).
Играет важнейшую роль в функционировании клеточного и гуморального
Слайд 46Иммуномодуляторы
препараты животного, микробного, дрожжевого и синтетического происхождения, обладающие специфической способностью стимулировать
Слайд 47Усиление общей сопротивляемости организма может в той или другой степени происходить
Слайд 48иммунологические свойства эндогенных соединений — лимфокинов, интерферонов (терапевтическую эффективность ряда лекарственных средств —
Слайд 49ИНТЕРФЕРОНЫ - группа низкомолекулярных гликопротеидов, вырабатываемых клетками человека или животных в
ЛИМФОКИНЫ - биологически активные вещества, синтезируемые и выделяемые всеми популяциями лимфоцитов под действием антигена или неспецифич. активатора, напр. лектина. С помощью Л. осуществляются кооперация, координация и регуляция функции клеток, участвующих в иммунном ответе.